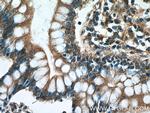
TCHP Antibody in Immunohistochemistry (Paraffin) (IHC (P))
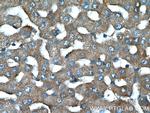
TCHP Antibody in Immunohistochemistry (Paraffin) (IHC (P))

Search
Proteintech
TCHP Polyclonal Antibody
{{$productOrderCtrl.translations['antibody.pdp.commerceCard.promotion.promotions']}}
{{$productOrderCtrl.translations['antibody.pdp.commerceCard.promotion.viewpromo']}}
{{$productOrderCtrl.translations['antibody.pdp.commerceCard.promotion.promocode']}}: {{promo.promoCode}} {{promo.promoTitle}} {{promo.promoDescription}}. {{$productOrderCtrl.translations['antibody.pdp.commerceCard.promotion.learnmore']}}

Please note: We are reviewing Western blot images included in the antibody testing data in our catalog, including those provided by third parties. Unless expressly labeled or annotated as “raw-unedited”, Western blot images included in the antibody testing data in our catalog may have been edited, optimized or otherwise adjusted for presentation.
产品信息
25931-1-AP
种属反应
宿主/亚型
分类
类型
抗原
偶联物
形式
浓度
规格
纯化类型
保存液
内含物
保存条件
运输条件
产品详细信息
Immunogen sequence: MALPTLPSY WCSQQRLNQQ LARQREQEAR LRQQWEQNSR YFRMSDICSS KQAEWSSKTS YQRSMHAYQR EKMKEEKRRS LEARREKLRQ LMQEEQDLLA RELEELRLSM NLQERRIREQ HGKLKSAKEE QRKLIAEQLL YEHWKKNNPK LREMELDLHQ KHVVNSWEMQ KEEKKQQEAT AEQENKRYEN EYERARREAL ERMKAEEERR QLEDKLQAEA LLQQMEELKL KEVEATKLKK EQENLLKQRW ELERLEEERK QMEAFRQKAE LGRFLRHQYN AQLSRRTQQI QEELEADRRI LQALLE (1-305 aa encoded by B C004285)
靶标信息
TCHP may act as a 'capping' or 'branching' protein for keratin filaments in the cell periphery. This protein may regulate K8/K18 filament and desmosome organization mainly at the apical or peripheral regions of simple epithelial cells.
仅用于科研。不用于诊断过程。未经明确授权不得转售。
生物信息学
蛋白别名: Mitochondrial protein with oncostatic activity; Mitostatin; Protein TCHP; Trichoplein keratin filament-binding protein; Tumor suppressor protein
基因别名: TCHP
Entrez Gene ID: (Human) 84260




